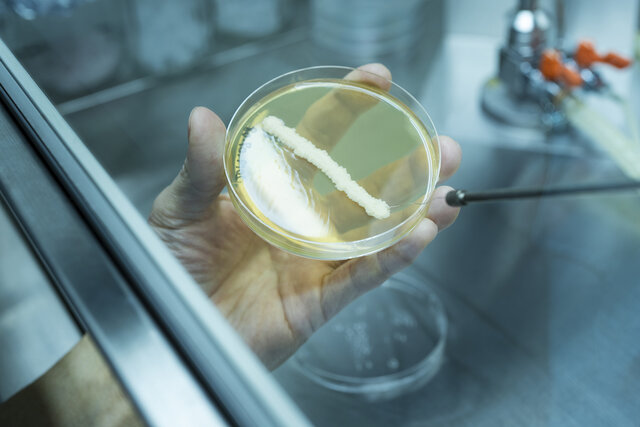
研究_自社酵母開発 研究_自社酵母開発

LOUNGE /
EAT
2020年5月25日
人生の節目や記念日に特別な日本酒を。「久保田 萬寿 自社酵母仕込」数量限定で新発売|朝日酒造
ASAHI-SHUZO|朝日酒造
米・精米・自社酵母にこだわった「久保田 萬寿」の新製品
朝日酒造は、「久保田」のプレミアムライン「久保田 萬寿」の新製品「久保田 萬寿 自社酵母仕込」を2020年5月19日(火)に数量限定で出荷した。
Text by YANAKA Tomomi|Edit by TSUCHIDA Takashi
重層的でエレガントな香りと、深くまろやかな味わい
2020年5月に会社創立100周年、「久保田」発売35周年を迎えた朝日酒造。このアニバーサリーイヤーを祝し、また近年、国内外での高まる日本酒ブームや、人生の節目の記念日に特別な日本酒を楽しみたいとのニーズを受け、35年間培った独自技術によるこだわりを表現した新たな日本酒「久保田 萬寿 自社酵母仕込」を生み出した。
「久保田 萬寿 自社酵母仕込」は、酒米、精米方法、自社酵母の3つにこだわった日本酒。蔵人自ら生産に携わった酒米「五百万石」を自社でプログラムした「原形精米」により、精米歩合40%まで磨き上げ、長年かけて育種した自社開発の酵母で仕込んだ。
その結果、重層的でエレガントな香りと、深くまろやかな味わいが広がり、存在感のある味わいながら、後味は透き通るようなキレが感じられる日本酒に。

デザインも「久保田 萬寿」を踏襲しながら、記念のひとときにふさわしい装いに仕上げられ、ボトルには一つ一つ手で封緘(かん)を施し、化粧箱はボトルとの調和を意識した深いこげ茶を基調に、ボトルと同じく和紙を貼ることで、より上質感・高級感が高められた。
成人や結婚、還暦など、人生の節目にふさわしい、これが最上級の「久保田」だ。
問い合わせ先
朝日酒造
Tel.0258-41-3777(月~金 10:00~17:00)
https://www.asahi-shuzo.co.jp/



特定名称|純米大吟醸
原料米|麹米・掛米:五百万石(精米歩合40%)
アルコール度数|15度
容量|720ml
価格|1万円(税別)